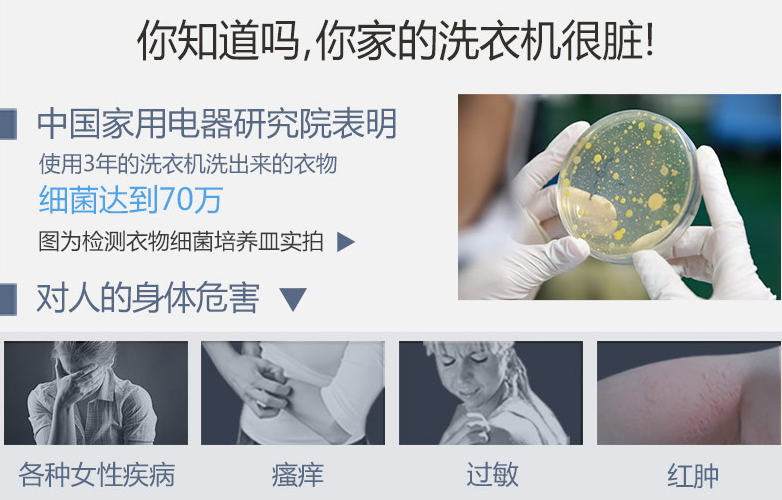

这家伙很懒,什么也没写!
都说华丽的皮囊千篇一律,有趣的灵魂万里挑一。比起海誓山盟地动天摇的壮烈,面对终要归于平淡的漫漫岁月,能够从平凡细节中不停找出生活中美好幸福的点滴,才是最难能可贵的心意。黄小厨正是凭借真好男人的魅力圈粉无数,给予家人满满的幸福,平凡朴实却踏实自在。在近期由TCL空调冰箱洗衣机独家冠名的《黄小厨的春夏秋冬》第四季中,黄小厨不仅现身传授独家美食秘籍,更与大家分享幸福回忆,讲述属于他的真好生活哲学。哪怕是针对日常洗护衣服的小事,黄小厨也手握妙招,不吝分享。

真好生活,不应该被衣物沾染油渍和污垢而大打折扣的!家中的洗衣机打着“清洁女王”的旗号,承包了一家人衣物的清洗工程,却可能时刻危害你和家人的健康!在我们都看不到的洗衣机内部,污垢和病菌已经堆积成灾,在洗衣机清洗衣物的时候,这些残存的污垢和病菌会直接污染洗衣水,导致衣物“越洗越脏”。
经研究发现,洗衣机内部的污垢病菌,其中包含大量的霉菌、大肠杆菌等一般致病菌是皮肤性疾病,妇科疾病等病症的隐患,长期不注意就有可能患上此类病症;以及绿脓杆菌、隐球菌等致病菌易对皮肤破损、伤口等造成感染或化脓性病变等危害;更为重要的是长期的金属污染会通过皮肤渗透易形成皮下组织病症隐患或皮肤病!这些致病菌不仅有可能引发皮肤疾病、妇科疾病,还会对皮肤破损、伤口造成感染或化脓性病变等危害。
黄小厨在节目中使用的TCL免污式洗烘一体滚筒洗衣机完美解决了这个问题,甚至可以说填补了一个行业内里程碑式的技术创新空缺。TCL免污式洗烘一体滚筒洗衣机,采用创新水封舱免污结构,彻底将内筒底三角架密封,三重水封设计内筒底始终光滑,防止腐蚀,完全隔离污染物;这一设计同时还可杜绝铝制支撑三角架的电化学反应,避免重金属二次污染衣物。而其平底免污洗内外桶底采用光滑圆润的平底设计,平整光滑圆润无死角,在衣物洗涤剂排水时,水流轻轻一冲,残留即刻被排出机外,洁净如新,彻底隔离去除洗衣机内部污垢残留。结构上实现了免污后,为了进一步将免污做到极致,TCL洗衣机研发团队还为免污式洗烘一体滚筒洗衣机加入一键95℃纯物理高温除菌技术,直观便捷的同时确保去除内筒中常见的大肠杆菌,金色葡萄球菌等致病菌,彻底杜绝对衣物的二次污染!






























参与讨论
评论列表 共有 0 条评论